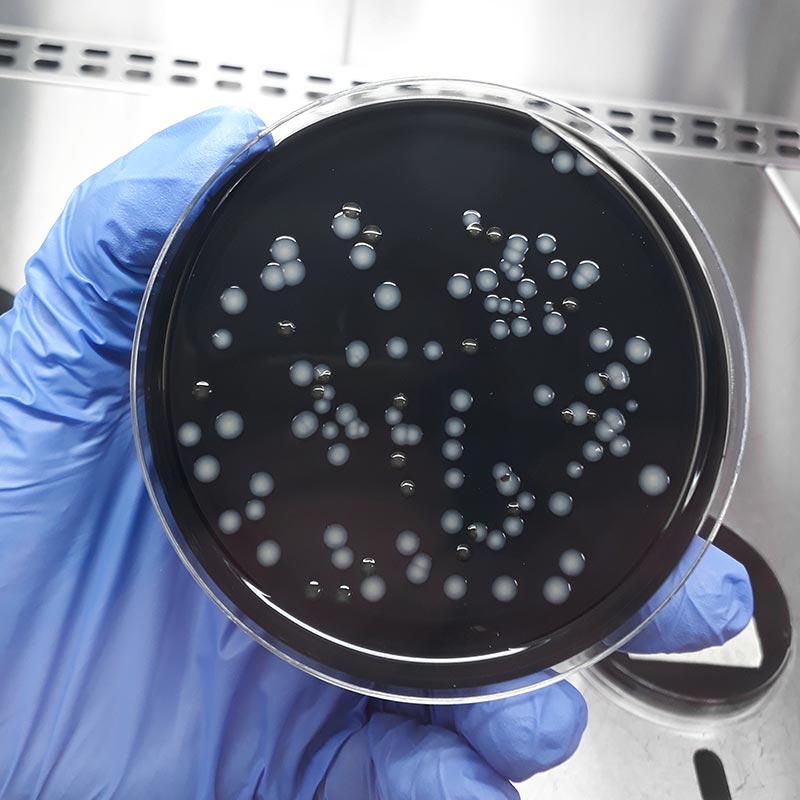
Analisi microbiologiche acque potabili e piscine - Consula Ambiente

Nel nostro laboratorio di microbiologia analizziamo campioni provenienti da diverse matrici biologiche, alimentari e ambientali, per identificare e quantificare gli organismi patogeni presenti nel campione esaminato.
In particolare, Consula Ambiente esegue analisi microbiologiche e chimiche su acque potabili e di piscina, i cui parametri sono definiti dal D. Lgs 18/2023 e dall’Accordo Stato-Regioni del 16/01/2003. L’obiettivo è accertare la qualità dell’acqua destinata al consumo umano e l’assenza di rischi per la salute legati al contatto diretto con le acque interessate.
Effettuiamo le analisi di tutti i parametri microbiologici (accreditati) e forniamo le dichiarazioni di conformità da esibire in caso di controlli da parte dell’autorità sanitaria.